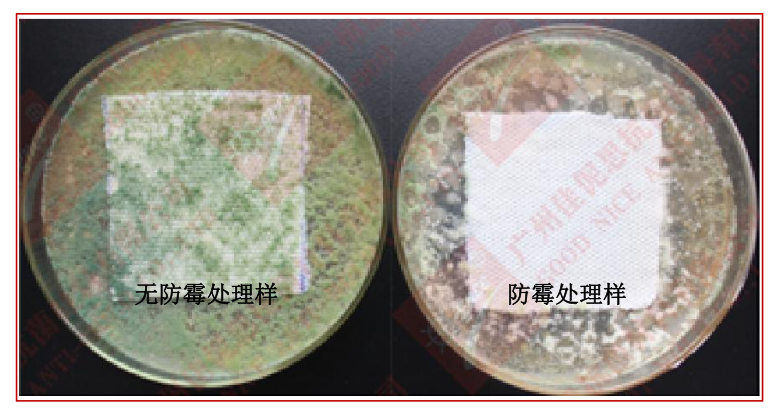
1676877770614.png image.png

概述
纺织防霉剂 AEM 5700-O-2 用于纺织物防霉加工处理,可使被处理后的纺织品具有优越的防霉性能。可以防止微 生物所引起的危害,避免织物出现发霉,保障产品质量,延长织物的使用寿命。
AEM5700-O-2 适用于棉、尼龙、聚酯等及各项纤维制品上进行防霉加工。其属于非释放型的处理剂,不渗失、不 游移,也不为微生物所消耗,可赋予材料表面优越的耐久的防霉性能。AEM5700-O-2 抗微生物处理剂可避免由霉菌、 藻类和酵母菌等引起的变质或变色等问题,能保持物品的“新鲜性”,因为它能抑制或抑制致臭细菌和霉菌的生长。 AEM5700-O-2 符合相关环保要求,经过相关 Reach、Rohs、不含 DMF 等相关环保检测认证。
适用范围
◎运动相关服饰:如休闲服、高尔夫球装、汗衫、内衣等;
◎家饰用品:如地毯、沙发、窗帘、床单、床罩、枕头套等;
◎运动器材:如护膝、护肘、束腰等;
◎厨房浴室:如浴帘、浴缸、抹布等。
使用方法
Ⅰ 织物的准备
1.为获得最佳效果,进行 AEM5700-O-2 加工时,最重要的是被处理物的表面需干净,无易脱落的物质,无其它污物;
2.织物掉纤率必须小于等于 1.5%,建议通过 AATCC97 进行测试;
3.若需柔软、手感、防水、防静电、防污整理时,防霉加工可先加工,如需同时处理,需先配伍。
Ⅱ 工作液的调配
1.使用前,首先请佩戴橡胶手套,避免直接接触原液,若不慎接触皮肤,请及时用肥皂水清洗 3-5 分钟。
2.纺织物进行防霉加工整理时,按照织物吸收药剂浓度来计算,若防霉能力需要达到 0 级,吸收药剂比例为 2%-3%。 例如:97 公斤布料需要 3 公斤 AEM5700-O-2 防霉剂。如果该织物的湿增重率为 90%(带液率),我们加入到水中 的防霉剂浓度则应该为 3.3%,即 96.7 公斤水需加入不少于 3.3 公斤的防霉剂。
公式 1:湿增重率=(吸水后的布重-布干重)÷布干重×100%,吸水后的布重为滚筒压轧过后的布重
公式 2: 吸收药剂比例=湿增重率×水中药剂浓度
如:水中药剂浓度=3%÷90%,得出为 3.3%,实际应稍大于此浓度。
Ⅲ 防霉加工
①将纺织物浸过工作液。
②压轧掉多余工作液,或采用脱水的方式进行。
③烘干(温度 120℃-180℃,具体温度、时间由产品和工艺流程决定)。
温馨提示
1.操作过程中请佩戴橡胶手套,本产品为高浓缩防霉剂,使用时不可用手直接接触,以免易过敏者产生皮肤接触过敏。
2.若不慎接触皮肤,请及时用肥皂水清洗。
3.与其它助剂拼用前,必须通过预备实验,充分确认与拼用药剂的相容性。
4.请尽量在 12 小时内将配制的处理液用完。
使用效果
-
环保木材防霉剂
点击收藏 查看详情 -
油漆防霉抗菌剂
点击收藏 查看详情 -
防霉喷剂
点击收藏 查看详情 -
纺织防霉抗菌剂
点击收藏 查看详情 -
皮革防霉抗菌剂
点击收藏 查看详情 -
涂料防霉剂(分散体)
点击收藏 查看详情






